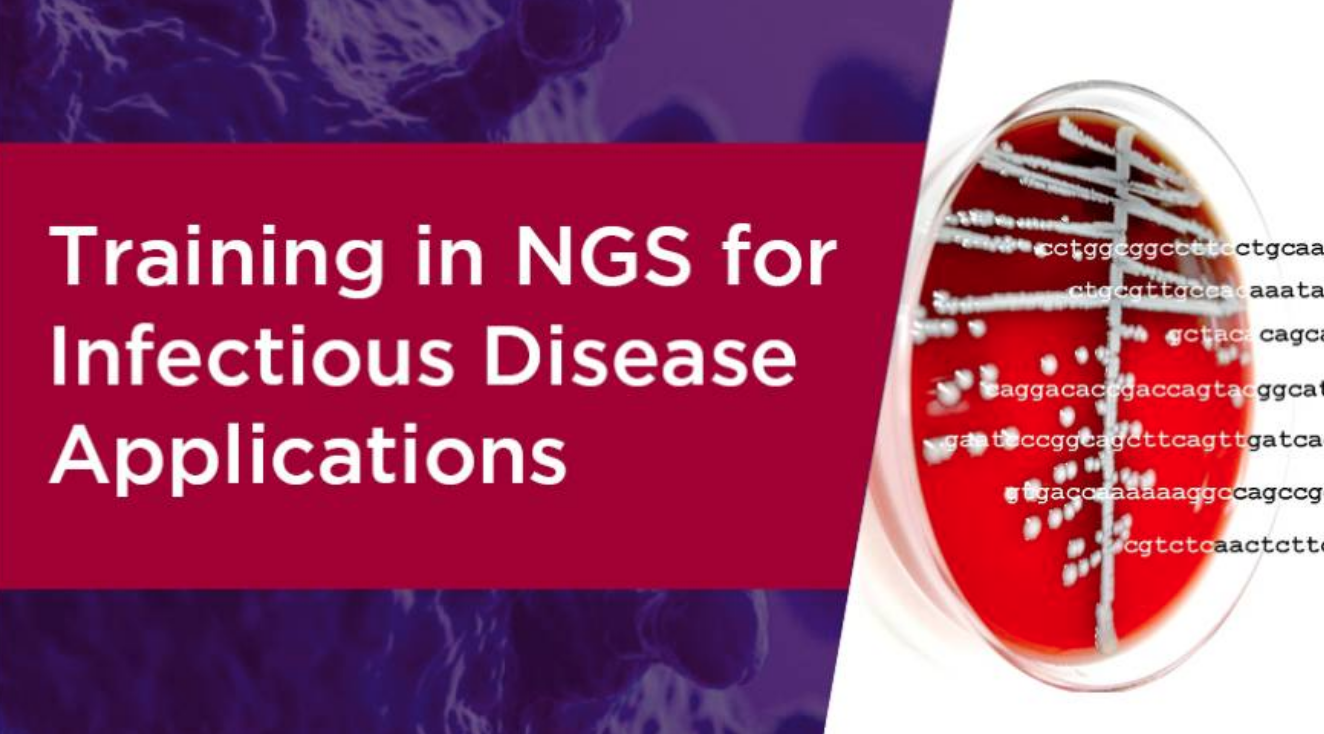

반응형
숙련도평가는 검사실간 비교를 통해 개별검사실 및 검사실군의 전체 검사단계에 대한 검사성능을 평가하는 것으로
외부정도관리 또는 신빙도조사로 부르기도 한다.
NGS 임상검사실은 검사 및 검사결과의 해석에 적합한 숙련도평가 프로그램에 참가하여야 하고, 적절한 숙련도 평가 프로그램에 참가할 수 없을 때에는, 검사실 내에서 이를 대체 할 수 있는 평가를 마련하여 시행하여야 한다. NGS 임상검사실 인증에서는 숙련도 항목에서 다음과 같은 사항을 평가한다.
가. NGS 검사 및 검사결과의 해석에 적합한 숙련도평가 프로그램에 참가여부
나. NGS 검사 및 검사결과의 해석에 적합한 숙련도평가 프로그램이 없는 경우, 대체 프로그램을 마련하여야 한다.
반응형
'차세대염기서열분석(NGS) 임상검사실 인증' 카테고리의 다른 글
| 차세대염기서열분석(NGS) 임상검사실인증 평가 분야 및 기준 (4) 인증 기준 (0) | 2025.12.26 |
|---|---|
| 차세대염기서열분석(NGS) 임상검사실인증 평가 분야 및 기준 (3) 검사성능 (0) | 2025.12.26 |
| 차세대염기서열분석(NGS) 임상검사실인증 평가 분야 및 기준 (1) 품질관리체계 (0) | 2025.12.26 |
| 차세대염기서열분석(NGS) 임상검사실인증 가이드라인 (0) | 2025.12.26 |
| 차세대염기서열분석(NGS) 임상검사실인증이란? (0) | 2025.12.26 |



